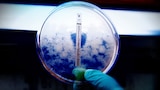

TV-PG
2017
3 Seasons
Reality Show
Maravillas de la Medicina
Something's Killing Me
: Doctors, scientists and law enforcement race to solve often life-threatening medical mysteries.
Los planes empiezan desde $9.99/mes.

1. Tiny Monsters
A seven-year-old boy's headache and high fever becomes a potentially deadly mystery.

2. My Wife Can't Breathe
After a doctor's death, a colleague helps solve the mystery of what led to her d...
3. Outbreak
When several patients begin to exhibit the same symptoms, doctors find themselve...

4. Family Secret
A mysterious phone call helps doctors uncover the truth behind a family's sudden...

5. What's Wrong with the Twins
Physicians discover a genetic disease that causes progressive neurological deter...

6. Mysterious Epidemic
A task force investigates the mysterious deaths of seven Chicago residents in 1982.
Quizá también te guste
Something's Killing Me
In an investigation of puzzling diseases and symptoms, doctors, scientists and law enforcement race to solve often life-threatening medical mysteries.
Starring:
BD Wong
Géneros:
Reality Show, Maravillas de la Medicina, Crímenes Reales
Episodios:
3 Seasons Available (18 Episodes)
Año de lanzamiento:
2017
Clasificación:
TV-PG
Encuentra tu plan ideal
Con anuncios
- HBO Max Básico con anuncios, Disney+ Básico, y Hulu (con anuncios)
- Resolución Full HD en HBO Max
- 2 dispositivos a la vez en HBO Max
Sin anuncios
- HBO Max Estándar, Disney+ Premium, y Hulu (sin anuncios)
- Resolución Full HD en HBO Max
- 2 dispositivos a la vez en HBO Max
- 30 descargas de HBO Max para disfrutar offline
Básico con anuncios
Ve el contenido con anuncios limitados.
- 2 dispositivos a la vez en HBO Max
- Resolución Full HD
En el plan Sin anuncios, ciertos contenidos en vivo y lineales contienen anuncios. Ahorros en función del precio mensual normal de cada servicio. Accede a cada servicio por separado. Los contenidos, funcionalidades y compatibilidad de dispositivos varían según el servicio. Deportes en vivo y CNN Max disponibles únicamente en planes selectos. La disponibilidad del plan varía según el proveedor de suscripción. Consulta con tu proveedor para obtener más detalles. Algunos partidos están sujetos a disponibilidad y pueden aplicar restricciones de transmisión. Aplican límites de descarga en ciertas categorías de contenido en HBO Max. Aplican condiciones adicionales.
Al suscribirte a este paquete, HBO Max compartirá tu dirección de correo electrónico y los detalles de tu suscripción con Disney+ y Hulu para fines de elegibilidad, marketing y otros propósitos. Para obtener más información sobre tus opciones, visita el Centro de privacidad.
El ahorro se calcula con base en el precio total del plan anual al inicio del período, en comparación con el precio del plan mensual a lo largo de 12 meses. En los planes Estándar y Premium, se incluyen anuncios en cierto contenido de televisión lineal. Deportes en vivo y CNN Max disponibles únicamente en planes selectos. La disponibilidad del plan varía según el proveedor de suscripción. Consulta con tu proveedor para obtener más detalles. Algunos partidos están sujetos a disponibilidad y pueden aplicar restricciones de transmisión. Se aplican límites de descarga a ciertas categorías de contenido. Consulta hbomax.com/information para más información